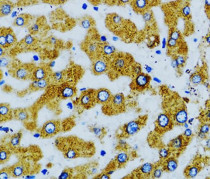

ARG41750
anti-SLC27A2 / FATP2 antibody
anti-SLC27A2 / FATP2 antibody for ICC/IF,IHC-Formalin-fixed paraffin-embedded sections,Western blot and Human,Mouse,Rat
概述
| 产品描述 | Rabbit Polyclonal antibody recognizes SLC27A2 / FATP2 |
|---|---|
| 反应物种 | Hu, Ms, Rat |
| 应用 | ICC/IF, IHC-P, WB |
| 宿主 | Rabbit |
| 克隆 | Polyclonal |
| 同位型 | IgG |
| 靶点名称 | SLC27A2 / FATP2 |
| 抗原物种 | Human |
| 抗原 | Recombinant fusion protein corresponding to aa. 30-200 of Human SLC27A2 / FATP2 (NP_001153101.1). |
| 偶联标记 | Un-conjugated |
| 別名 | Fatty-acid-coenzyme A ligase, very long-chain 1; Long-chain-fatty-acid--CoA ligase; FATP-2; EC 6.2.1.-; HsT17226; VLCS; hFACVL1; Very long-chain acyl-CoA synthetase; Fatty acid transport protein 2; VLACS; FATP2; Very long-chain-fatty-acid-CoA ligase; ACSVL1; EC 6.2.1.3; THCA-CoA ligase; FACVL1; Solute carrier family 27 member 2 |
应用说明
| 应用建议 |
|
||||||||
|---|---|---|---|---|---|---|---|---|---|
| 应用说明 | * The dilutions indicate recommended starting dilutions and the optimal dilutions or concentrations should be determined by the scientist. | ||||||||
| 阳性对照 | HepG2 | ||||||||
| 实际分子量 | ~ 70 kDa |
属性
| 形式 | Liquid |
|---|---|
| 纯化 | Affinity purified. |
| 缓冲液 | PBS (pH 7.3), 0.02% Sodium azide and 50% Glycerol. |
| 抗菌剂 | 0.02% Sodium azide |
| 稳定剂 | 50% Glycerol |
| 存放说明 | For continuous use, store undiluted antibody at 2-8°C for up to a week. For long-term storage, aliquot and store at -20°C. Storage in frost free freezers is not recommended. Avoid repeated freeze/thaw cycles. Suggest spin the vial prior to opening. The antibody solution should be gently mixed before use. |
| 注意事项 | For laboratory research only, not for drug, diagnostic or other use. |
生物信息
| 数据库连接 | |
|---|---|
| 基因名称 | SLC27A2 |
| 全名 | solute carrier family 27 (fatty acid transporter), member 2 |
| 背景介绍 | The protein encoded by this gene is an isozyme of long-chain fatty-acid-coenzyme A ligase family. Although differing in substrate specificity, subcellular localization, and tissue distribution, all isozymes of this family convert free long-chain fatty acids into fatty acyl-CoA esters, and thereby play a key role in lipid biosynthesis and fatty acid degradation. This isozyme activates long-chain, branched-chain and very-long-chain fatty acids containing 22 or more carbons to their CoA derivatives. It is expressed primarily in liver and kidney, and is present in both endoplasmic reticulum and peroxisomes, but not in mitochondria. Its decreased peroxisomal enzyme activity is in part responsible for the biochemical pathology in X-linked adrenoleukodystrophy. Alternatively spliced transcript variants encoding different isoforms have been found for this gene. [provided by RefSeq, Apr 2009] |
| 生物功能 | Acyl-CoA synthetase probably involved in bile acid metabolism. Proposed to activate C27 precurors of bile acids to their CoA thioesters derivatives before side chain cleavage via peroxisomal beta-oxidation occurs. In vitro, activates 3-alpha,7-alpha,12-alpha-trihydroxy-5-beta-cholestanate (THCA), the C27 precursor of cholic acid deriving from the de novo synthesis from cholesterol. Does not utilize C24 bile acids as substrates. In vitro, also activates long- and branched-chain fatty acids and may have additional roles in fatty acid metabolism. May be involved in translocation of long-chain fatty acids (LFCA) across membranes (By similarity). [UniProt] |
| 细胞定位 | Endoplasmic reticulum membrane; Multi-pass membrane protein. Peroxisome membrane; Multi-pass membrane protein. Note=Peripheral membrane associated with the lumenal side of peroxisomes. [UniProt] |
| 预测分子量 | 70 kDa |
检测图片 (2) Click the Picture to Zoom In
-
ARG41750 anti-SLC27A2 / FATP2 antibody IHC-P image
Immunohistochemistry: Paraffin-embedded Human liver tissue stained with ARG41750 anti-SLC27A2 / FATP2 antibody at 1:100 dilution.
-
ARG41750 anti-SLC27A2 / FATP2 antibody WB image
Western blot: 25 µg of HepG2 cell lysate stained with ARG41750 anti-SLC27A2 / FATP2 antibody.